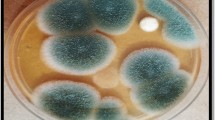

Abstract
Dyes released by the textile industries pose a threat to the environmental safety. Recently, dye decolorization through biological means has gained impetus as these are cheap and can be applied to wide range of dyes. The main focus of the present investigation is to evaluate the bioremediation potential of Aspergillus flavus isolated from textile dye contaminated soil for the decolorization of synthetic acid dyes. Among the isolated four fungal strains namely Aspergillus flavus, Fusarium oxysporum, Rhizopus sp. and Aspergillus terrus, Aspergillus flavus was capable of decolorising 96 and 97% for Acid Blue (AB) 193 and Acid Violet (AV) 90, respectively under optimum conditions of pH 6.0 and temperature 25 °C. Hence from the results, it can be concluded that this fungus can be used as eco-friendly and economically effective tool to decolorize textile dye effluents.
Access provided by Autonomous University of Puebla. Download chapter PDF
Similar content being viewed by others
Keywords
1 Introduction
Synthetic dyes are widely used in textile dyeing, paper printing, color photography, pharmaceutical, food, cosmetic and leather industries (Rafii et al. 1990; Kuhad et al. 2004; Rodriguez Couto 2009). Since 1856, over 105 different dyes have been produced worldwide with an annual production of over 7 × 105 metric tons (Chen et al. 2003). Of all the familiar dyestuffs in the world, azo dyes make up about a half, making them the largest group of synthetic colorants that are released into the environment (Zhao and Hardin 2007; Sen et al. 2016). Effluents from the textile industries containing dye are highly coloured and are therefore visually identifiable (Kılıç et al. 2007) and are visible even at 1 mg/ml concentration (Pandey et al. 2007). The discharge of colored effluents into the environment is detrimental, not only because of their colour but due to the lethal and carcinogenic properties of dye compounds and their end products (Weisburger 2002).
Different approaches are available for the remediation of dye effluents which include a number of physical, chemical and biological methods namely, oxidation and reduction, adhesion, photocatalysis, coagulation, microbial degradation methods, etc., (Fu and Viraraghavan 2001). Nevertheless, these technologies are usually ineffectual in the removal of color, costly and less adaptable to an extensive range of dye waste waters (Banat et al. 1996). Biological methods are generally considered environmentally approachable as they can lead to complete mineralization of organic pollutants at low cost (Pandey et al. 2007).
Among the biological methods, bioremediation is promising tool for the elimination of toxic pollutants and it is the application of microorganisms (fungi, bacteria, actinomycetes, yeasts and algae). Microorganisms which are naturally having the tolerant ability to utilise dye compounds as their sole energy source are of extraordinary interest for scientific community to eliminate the environmental contaminants that results from the industrial sources (Ali et al. 2010). Dye degradation by bacteria predominantly depends on the enzymatic transformation where the azo dyes are cleaved with the enzyme azo-reductase along with its coenzyme (Zimmermann et al. 1982; Moutaouakkil et al. 2003; Saroj et al. 2015), whereas fungal degradation of azo dyes are catalyzed by extracellular enzymes ie., ligninolytic peroxidases (Young and Yu 1997; Selvam et al. 2003; Máximo et al. 2003). Although bacterial dye degradation have been widely studied, in recent days fungal have gained importance in dye degradation due to their unique extra cellular enzyme systems. Fungi are capable of degrading the complex dye structures when compared with bacteria (Forss and Welander 2009). Fungal mycelia have an additive advantage over single cell organism by solubilizing the insoluble substrates by producing extracellular enzymes (Gajera et al. 2015). Higher concentration of dye toxicants can be easily degraded by fungi due to their advantageous enzyme arrangements and improved cell to surface ratio. Various studies have reported that fungi like white rot decolorize the synthetic dyes and the processes are mediated by lignin peroxidase (Ollikka et al. 1993), manganese peroxidase (Heinfling et al. 1998) and laccase (Abadulla et al. 2000; Soares et al. 2001; Murugesan and Kalaichelvan 2003). Based on the fact that the fungi have the capacity of degrading wide variety of organic and inorganic dye components, the present study was carried out to isolate and screen fungal strains for decolorization of azo dyes (AB 193 and AV 90) and optimize the pH and temperature for better understanding the process.
2 Materials and Methods
2.1 Dye Stuffs and Chemicals
Acid Blue 193 (AB 193) and Acid violet 90 (AV 90) commonly used in local textile processing industries were obtained from Rajasthan Dye Chemical Ltd., Chennai, India. Dyes were dissolved in double distilled water to prepare a stock concentration (1000 mg L−1) and solutions of the desired concentrations were obtained by successive dilutions. Media components and chemicals were purchased from Himedia Labs, Bombay, India.
2.2 Sample Collection
Soil samples were collected from the textile industry at Tirupur, Tamil Nadu, India and were stored at 4 °C until further process.
2.3 Screening and Identification of AB 193 and AV 90 Tolerant Fungi
The soil samples were serially diluted using sterile distilled water and from the 10–2 to 10–7 dilutions, 0.1 mL of sample was transferred onto Czapek-Dox agar plate containing AB 193 and AV 90 (50 mg L−1). Spread plate method was performed and the plates were incubated at 30 ± 1 °C for 4 days. Fungal colonies were identified using steriobinocular microscope. Fungi which showed decolorization in Czapek-Dox agar medium were screened further by transferring in a fresh Czapek-Dox agar plates containing different dye concentrations (50 and 100 mg L−1). Colonies were selected on the basis of their ability to decolorize the dye on the plates. Isolated colonies were then subsequently transferred to Czapek-Dox agar for further study. Fungal strains with greatest dye tolerance capacity were identified by its different biochemical characteristics and structural arrangements. Wet mount was prepared by suspending culture in a few drops of lacto phenol cotton blue solution. The slides were examined under high and low power magnification with the aid of a dissecting microscope (Cappuccino and Sherman 2004).
3 Decolorization Experiments
3.1 Optimization of Incubation Time on Decolorization of Azo Dyes
The isolated fungus was tested for its ability to decolorize AB 193 and AV 90 (100 mg L−1). About 50 mL of C-limited Czapek-Dox medium was amended separately with the dyes and subsequently inoculated with 5 ml spore suspension (108 spore/ml) from a slant culture. The flasks were incubated at 30 ± 1 ºC for 12 days on a rotary shaker (150 rpm) and the samples were withdrawn at 2 days intervals and centrifuged at 10,000 rpm for 10 min. Supernatant collected was assessed for the decolorization of AB 193 and AV90 in UV–Vis spectrophotometer (UV–Vis 1700, Shimadzu, Japan) at its maximum absorbence wave length of 586 and 526 nm, respectively. Two control flasks (i) dye + medium without inoculum and (ii) medium with inoculum without dye were maintained. The percentage decolorization was calculated according to the following formula Bergsten-Torralba et al. (2009)
Decolorization (%) = Initial OD—Final OD X 100/Initial OD… 0.11.1
3.2 Optimization of pH and Temperature on Decolorization of Azo Dyes
For optimization of physical parameters, the fungal inoculated shake flasks were incubated for 10 days at different initial pH values from 2 to 10 (2, 4, 6, 8, 10) to determine the optimal pH for dye decolorization. For investigating the effect of temperature, the shake flasks inoculated with fungal inoculum were incubated at varying temperatures from 20 to 35 ºC (20, 25, 30 35 ºC) at optimum pH for 10 days. The experimental conditions were maintained as mentioned earlier. Samples were withdrawn at regular intervals and analyzed for color removal.
3.3 Optimization of Initial Dye Concentration on Decolorization of Dyes
Fungal isolates were added into a 250 mL medium containing varying concentrations (25, 50, 75, 100 and 125 mg L−1) of AB 193 and AV 90 individually. At optimum pH and temperature, the flasks were incubated in a rotary shaker (Orbitek) at 150 rpm.
4 Results and Discussion
4.1 Screening and Selection of Dye Tolerant Fungi
In the present study one fungal strain was selected among the four isolated strains, Aspergillus flavus, Fusarium oxysporum, Rhizopus sp. and Aspergillus terrus, Aspergillus flavus for the decolorization of AB 193 and AV 90 based on its high dye decolorization ability (Table 1). This selected strain was identified as Aspergillus flavus based on various cultural characteristics, morphology and by the presence of conidiospores (Table 2). It was observed that the Aspergillus flavus and Rhizopus species tolerated upto 100 mg L−1 of AB 193 and in case of AV 90, Aspergillus flavus and Fusarium oxysporum tolerated upto 100 mg L−1, respectively. Above results reveals that decolorization by Aspergillus flavus was found to be high (100 mg/L) for both AB 193 and AV 90. Hence for further studies, Aspergillus flavus was selected as an efficient strain for decolorization.
In present study A. flavus decolorized dye by forming clear zone on agar plates, which may due to their extracellular, nonspecific and nonstereoselective enzyme system (Hofrichter 2002). Fungal decolorization capacity can be confirmed by their ability to form a clear halo zone on agar plates containing dye AB 193 or AV 90 (Yamini et al. 2012). Previous studies disclose that fungal strains were able to decolorize dyes on agar plates (Jarosz-Wilkolazka et al. 2002; Eichlerova et al. 2006).
4.2 Effect of Incubation Time on AB 193 and AV 90 Decolorization by Aspergillus Flavus
Initially, the decolorization was very low on the second day that is 42 and 43% for AB 193 and AV 90, respectively. Then it gradually increased with increase in incubation time. The decolorization efficiencies of Aspergillus flavus were 48 and 45% for AB 193 and AV90, respectively and it slowly increased and reached maximum of 96 and 97% within 10 days of incubation time as represented in Figs. 1 and 2.
4.3 Effect of pH and Temperature for AB 193 and AV 90 Decolorization by Aspergillus Flavus
At initial pH 2, the decolorization of both dyes was low. Maximum decolorization of AB 193 (96%) and AV 90 (97%) were observed around pH 6 by Aspergillus flavus (Fig. 3 and 4). When the pH was increased to 10 the decolorization of dyes was decreased in both cases. It is observed that the fungus showed higher decolorization efficiency in acidic condition for both the dyes.
The pH of the medium plays a vital role in decolorization of dyes. The effects of pH may be related to the transport of dye molecule across the cell membrane (Kodam et al. 2005). Study of Asgher et al. (2008) shows Schizophyllum commune can work in acidic media, and decolorize maximum (77%). Murugesan and Kalaichelvan (2003) also reported that G. lucidum laccase prefers acidic orange for higher decolorization extent. The maximal decolorization was observed at pH 4.0 for both RB-5 and Remazol Brilliant Blue R (RBBR). However Yesilada et al. (2003) studied that Funalia troggii had effective decolorization capacity in broad pH range of 6–11 and this results reveals that the optimum pH of fungus may be affected by its chemical nature.
Dye decolorization was evaluated at varying temperatures (20–35 ºC) for AB 193 and AV 90 and the results are shown in Figs. 5 and 6. The fungus exhibited better dye decolorization at 25 ºC for both the dyes in 10 days of incubation time. At 20 ºC, decolorization of dyes was 50 and 60% for AB193 and Av 90, respectively. The decreasing trend of dye decolorization of 42 and 74% were observed at higher temperatures 30 ºC for AB 193 and 35 ºC AV 90, respectively.
The decolorization of dye varies at different temperaures, since the temperature changes lead to a sudden alteration in the activation energy which is concerned with the cell viability (Yu et al. 2001). Decolorization of A. flavus reached maximum within 10 days at lower concentrations of dye which indicates that increasing the dye concentration gradually decreases the decolorization rate, probably due to the toxic effect of dyes with regard to the fungal biomass concentration (Tony et al. 2009).
The dye decolorization is inversely related to the concentration of the dye due to which it shows inhibitory effects of high dye stuffs in the solution. Similar results has been observed in decolorization of acid fuchsin, acid violet and evans blue up to 83–91% within 2 h whereas it slowly decreased to 45% for bromophenol blue within 8 h. The difference in the decolorization efficiencies for the dyes is from the different redox potentials of the colored substrates (Chivukula and Renganathan 1995).
4.4 Effect of Initial Dye Concentration on AB 193 and AV 90 Decolorization
The decolorization efficiencies of Aspergillus flavus against AB 193 and AV 90 reached 100% till 100 mg/L whereas when the concentration of dye was increased slowly, decreased decolorization was observed which is shown in Figs. 7 and 8. It was observed that at concentrations 100 mg/L the decolorization was quite efficient, and it reached up to 96% (AB 193) and 97% (AV 90) respectively. When the concentration was gradually increased to 125 mg/L, the decolorization of AB 193 and AV 90 decreased up to 65 and 56%, respectively.
The growth of the fungi may be affected by the presence of dyes at toxic concentrations and in turn shows effect on decolorization efficiency. Also, the structure of the dye is also influential in deciding the extent to which dye is decolorized. As reported earlier (Kapdan et al. 2000) that at lower dyestuff concentration 0.05% complete decolorization of everzol turquoise blue G by C. versicolor was observed whereas only partial decolorization could be achieved for dyestuff concentrations above 0.05%. Phanerochaete chrysosporium showed a color removal efficiency of 95–100% on direct blue 15 in repeated batches (Pazarlioglu et al. 2005) following first order kinetics with respected to initial concentrations of dye.
5 Conclusion
In summary, the present study indicates that the fungal isolate Aspergillus flavus is an excellent strain for the decolorization of azo dyes. The optimum pH and temperature for enhanced decolorization is at 6 and 25 ºC, respectively. This implies the fungus Aspergillus flavus serve as a potential candidate for the decolorization of textile effluents containing the dyes. In future, further approach has to be focused on enzyme responsible for decolorization of azo dyes.
References
Abadulla E, Tzanov T, Costa S, Robra K-H, Cavaco-Paulo A, Gübitz GM (2000) Decolorization and detoxification of textile dyes with a laccase from Trametes hirsuta. Appl Environ Microbiol 66:3357–3362
Ali H (2010) Biodegradation of synthetic dyes—a review. Water Air Soil Pollut 213:251–273
Asgher M, Bhatti HN, Ashraf M, Legge RL (2008) Recent developments in biodegradation of industrial pollutants by white rot fungi and their enzyme system. Biodegrad 19:771
Banat IM, Nigam P, Singh D, Marchant R (1996) Microbial decolorization of textile-dyecontaining effluents: a review. Bioresour Technol 58(3):217–227
Bergsten-Torralba LR, Nishikawa MM, Baptista DF, Magalhães DP Silva da M (2009) Decolorization of different textile dyes by Penicillium simplicissimum and toxicity evaluation after fungal treatment. Braz J Microbiol 40:808–817
Cappuccino J, Sherman N (2004) In Cummings B (ed) Microbiology: a laboratory manual, 7 edn. San Francisco, California, USA
Chen K-C, Wu J-Y, Liou D-J, Hwang S-CJ (2003) Decolorization of the textile dyes by newly isolated bacterial strains. J Biotechnol 101:57–68
Chivukula M, Renganathan V (1995) Phenolic azo dye oxidation by laccase from Pyricularia oryzae. Appl. Environ. Microbiol. 61:4374–4377
Eichlerová I, Homolka L, Nerud F (2006) Synthetic dye decolorization capacity of white rot fungus Dichomitus squalens. Bioresour Technol 97:2153–2159
Forss J, Welander U (2009) Decolourization of reactive azo dyes with microorganisms growing on soft wood chips. Int Biodeterior Biodegrad. 63:752–758
Fu Y, Viraraghavan T (2001) Fungal decolorization of dye wastewaters: a review. Bioresour Technol 79:251–262
Gajera HP, Bambharolia RP, Hirpara DG, Patel SV, Golakiya BA (2015) Molecular identification and characterization of novel Hypocrea koningii associated with azo dyes decolorization and biodegradation of textile dye effluents. Process Safe Environ Protec 98:406–416
Heinfling A, Martínez MJ, Martínez AT, Bergbauer M, Szewzyk U (1998) Transformation of industrial dyes by manganese peroxidases from Bjerkandera adusta and Pleurotus eryngii in a manganese-independent reaction. Appl Environ Microbiol 64:2788–2793
Hofrichter M (2002) Review: lignin conversion by manganese peroxidase (MnP). Enzyme Microb Technol 30:454–466
Jarosz-Wilkołazka A, Malarczyk E, Pirszel J, Skowroński T, Leonowicz A (2002) Uptake of cadmium ions in white-rot fungus trametes versicolor: effect of Cd (ii) ions on the activity of laccase. Cell Biol Int 26:605–613
Kapdan IK, Kargi F, McMullan G, Marchant R (2000) Biological decolorization of textile dyestuff by coriolus versicolor in a packed column reactor. Environ Technol 21:231–236
Kılıç NK, Nielsen JL, Yüce M, Dönmez G (2007) Characterization of a simple bacterial consortium for effective treatment of wastewaters with reactive dyes and Cr(VI). Chemosphere 67:826–831
Kodam KM, Soojhawon I, Lokhande PD, Gawai KR (2005) Microbial decolorization of reactive azo dyes under aerobic conditions. World J Microbiol Biotechnol 21:367–370
Kuhad RC, Sood N, Tripathi KK, Singh A, Ward OP (2004) Developments in microbial methods for the treatment of dye effluents. In: Microbiology. Academic Press, p. 185–213.
Máximo C, Amorim MTP, Costa-Ferreira M (2003) Biotransformation of industrial reactive azo dyes by Geotrichum sp. CCMI 1019. Enzyme Microb Technol 32:145–151
Moutaouakkil A, Zeroual Y, Zohra Dzayri F, Talbi M, Lee K, Blaghen M (2003) Purification and partial characterization of azoreductase from Enterobacter agglomerans a. Biochem Biophys 413:139–146
Murugesan K, Kalaichelvan PT (2003) Synthetic dye decolourization by white rot fungi. Indian J Esp Biol 41(09)
Ollikka P, Alhonmäki K, Leppänen V-M, Glumoff T, Raijola T, Suominen I (1993) Decolorization of Azo, Triphenyl Methane, Heterocyclic, and Polymeric Dyes by Lignin Peroxidase Isoenzymes from Phanerochaete chrysosporium. Appl Environ Microbiol 59:4010–4016
Pandey A, Singh P, Iyengar L (2007) Bacterial decolorization and degradation of azo dyes. Int Biodeterior Biodegrad 59:73–84
Pazarlıoǧlu NK, Sariişik M, Telefoncu A (2005) Laccase: production by Trametes versicolor and application to denim washing. Process Biochem 40:1673–1678
Rafii F, Franklin W, Cerniglia CE (1990) Azoreductase activity of anaerobic bacteria isolated from human intestinal microflora. Appl Environ Microbiol 56:2146–2151
Rodríguez Couto S (2009) Dye removal by immobilized fungi Biotechnol Adv 27:227–235
Saroj S, Dubey S, Agarwal P, Prasad R, Singh RP (2015) Evaluation of the efficacy of a fungal consortium for degradation of azo dyes and simulated textile dye effluents. Sustain Water Resour Manag 1:233–243
Selvam K, Swaminathan K, Chae K-S (2003) Decolourization of azo dyes and a dye industry effluent by a white rot fungus Thelephora sp. Bioresour Technol 88:115–119
Sen SK, Raut S, Bandyopadhyay P, Raut S (2016) Fungal decolouration and degradation of azo dyes: a review. Fungal Biol. Rev. 30:112–133
Soares GMB, de Amorim MTP, Costa-Ferreira M (2001) Use of laccase together with redox mediators to decolourize Remazol Brilliant Blue R. J Biotechnol Biotechnol Textile Indus Perspect New Millenn 89:123–129
Tony BD, Goyal D, Khanna S (2009) Decolorization of textile azo dyes by aerobic bacterial consortium. Int Biodeterior Biodegrad 63:62–469
Weisburger JH (2002) Comments on the history and importance of aromatic and heterocyclic amines in public health. Mutatation res/fundamental and molecular mechanisms of mutagenesis. In: 8th international conference on carcinogenic/mutagenic n-substituted aryl compounds 506–507, 9–20
Yamini D, Sivakami V, Soundarya M, Kumar DM (2012) Biodegradation of textile dyes, direct brilliant violet and direct greenish blue by Aspergillus sp. J Acad Indus Res 1(6):329–331
Yesilada O, Asma D, Cing S (2003) Decolorization of textile dyes by fungal pellets. Process Biochem 38:933–938
Young L, Yu J (1997) Ligninase-catalysed decolorization of synthetic dyes. Water Res 31:1187–1193
Yu J, Wang X, Yue PL (2001) Optimal decolorization and kinetic modeling of synthetic dyes by Pseudomonas strains. Water Res 35(15):3579–3586
Zhao X, Hardin IR (2007) HPLC and spectrophotometric analysis of biodegradation of azo dyes by Pleurotus ostreatus. Dyes Pigm 73:322–325
Zimmermann T, Kulla HG, Leisinger T (1982) Properties of purified orange II Azoreductase, the enzyme initiating azo dye degradation by pseudomonas KF46. Eur. J. Biochem. 129:197–203
Author information
Authors and Affiliations
Corresponding author
Editor information
Editors and Affiliations
Rights and permissions
Copyright information
© 2021 The Author(s), under exclusive license to Springer Nature Switzerland AG
About this chapter
Cite this chapter
Dexilin, M., Gowri Manogari, B., Kaliannan, T. (2021). Optimization of Culture Conditions for Enhanced Decolorization of Azo Dyes by Aspergillus flavus Isolated from Dye Contaminated Soil. In: Marimuthu, P.D., Sundaram, R., Jeyaseelan, A., Kaliannan, T. (eds) Bioremediation and Green Technologies. Environmental Science and Engineering(). Springer, Cham. https://doi.org/10.1007/978-3-030-64122-1_11
Download citation
DOI: https://doi.org/10.1007/978-3-030-64122-1_11
Published:
Publisher Name: Springer, Cham
Print ISBN: 978-3-030-64121-4
Online ISBN: 978-3-030-64122-1
eBook Packages: Earth and Environmental ScienceEarth and Environmental Science (R0)